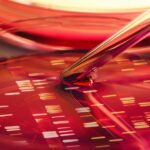

Jak obiecałem w ostatni felietonie powracam do tematu, który jest obecnie na topie w onkologii, czyli tworzenia komórek modyfikowanych genetycznie do zwalczania nowotworów. Uzyskanie tego typu komórek przypomina szkolenie najwyższej klasy wojsk dowodzonych przez doskonale przygotowanych oficerów.
Komórki nowotworowe robią absolutnie wszystko, żeby uniknąć wyśledzenia i zniszczenia. Stosują w związku z tym szereg różnych „sztuczek”. Przebierają się (nakładają na siebie białka, które chronią je przed wykryciem), gubią dowody osobiste (chowają w głębi swoich komórek białka, dzięki którym mogą zostać rozpoznane przez układ odpornościowy), wreszcie jako dość brutalni mordercy zabijają przy pomocy różnych narzędzi komórki układu odpornościowego poprzez specjalne molekuły (cząsteczki białkowe, które mają na powierzchni). A potrafią posunąć się jeszcze dalej. Uciekają się też do przekupstwa i przeciągają na swoją stronę część komórek odpornościowych, które je rozpoznały – słowem prawie korupcja.
Nowotwór potrafi być bardzo sprytny, potrafi „czaić się” w naszych organizmach nierozpoznany i nie dający żadnych objawów całymi latami. To absolutny mistrz kamuflażu. Z jednej strony zachowuje się jak szpieg doskonały, ale jest też bezwzględnym mordercą, który potrafi długo czekać na okazję do ataku.
Dość powiedzieć, że od chwili powstania komórki nowotworowej, w chorobie zwanej szpiczakiem mnogim, do jej ujawnienia się klinicznego może minąć nawet 30-40 lat! I jak tu walczyć z takim przeciwnikiem? Nie dość, że morderczy, to jeszcze nieludzko cierpliwy i genialnie zamaskowany.

Zdjęcie ilustracyjne / Fot. iStock / LL28
A jednak wojna
Do tej pory używaliśmy różnych metod walki: chirurgia, chemioterapia, radioterapia itp. Chemioterapia niestety nie działa wybiórczo i potrafi uszkodzić również prawidłowe komórki naszego organizmu. Oddziałuje głównie na te, które szybko się namnażają (jest to cechą większości, choć nie wszystkich nowotworów), celuje bowiem w ich kod genetyczny (DNA). Niestety uszkadza przy okazji DNA „zdrowych komórek”, co czasem w konsekwencji prowadzić może do długotrwałych, niekorzystnych zmian w naszym zdrowiu. I to nawet po zakończeniu terapii. Podobnie jest z radioterapią. Obie te metody ponadto poprzez brak selektywności działania mają zatem też ograniczone ilości dawek, które możemy zastosować. Ich przekroczenie może być katastrofalne dla nowotworu, ale również nieakceptowalne dla osoby chorej i mogące ją narazić na ciężkie powikłania.
A przecież można inaczej. Po dziesiątkach lat badań i rozwoju takich dziedzin jak immunologia, genetyka molekularna, inżynieria genetyczna i biotechnologia, udało się stworzyć zupełnie inne podejście terapeutyczne. Skoro buntownicy są tak przebiegli, to trzeba nasze wojska wysłać do szkoły oficerskiej. Tam nauczą się wywiadu, walki i równej bezwzględności w stosunku do wroga, jaką on ma w stosunku do nas. Przecież bijemy się o przeżycie, więc szkolenie musi być bardzo dobre, staranne i wszechstronne.
Zacznijmy zatem od kamuflażu. Komórki nowotworowe, jak napisałem wcześniej, chowają swoje „dowody osobiste” (swoiste białka powierzchniowe) oraz wydzielają substancje uspokajające komórki układu odpornościowego. Szczególnie dotyczy to limfocytów T – naszych głównych żołnierzy walczących z nowotworem. Co zatem zrobić, skoro limfocyty te zostają tak „oślepione”? No cóż – trzeba im zafundować okulary, noktowizory, skanery i co tam tylko jeszcze trzeba. Łatwo powiedzieć, ale jak to zrobić?
„Oczy” limfocytów
Otóż każdy limfocyt ma „oczy” – receptory, za pomocą których bada powierzchnię napotkanych komórek i dzięki temu jest w stanie sprawdzić, czy ma do czynienia z „uczciwym obywatelem” czy buntownikiem. Buntownik jednak go oślepia. Zatem jajogłowi naukowcy wymyślili, że trzeba poprawić im te oczy i założyć wspomniane okulary. Jak? Dosłownie to trudno byłoby zrobić tak małe szkła, że o oprawkach nie wspomnę (sic!). Każde białko – a receptor, czyli oczy limfocytu jest białkiem – jest w naszym organizmie kodowany przez określony gen. Zatem zamiast zmieniać białko trzeba zmienić gen. Naukowcy potrafią to robić już od dłuższego czasu, a ostatnio nabrali takiej wprawy w tej dziedzinie, że potrafią przepisywać lub tworzyć nowe geny niemal z taką precyzją, jak informatycy kod programu do komputera.
Zatem z punktu widzenia biotechnologii trzeba dodać do kodu genetycznego „ślepego” limfocytu takie geny, które zakodują odpowiedni receptor, a ten rozpozna delikwenta nawet, gdy ma podrobiony lub ukryty dowód osobisty. A zatem – założyć limfocytowi okulary. Świetnie! Aha, jeszcze jeden drobiazg – jak dostarczyć te okulary do właściwych limfocytów? No i zaczęła się górka.
Udało się jednak. Trzeba tylko podpatrzeć troszkę naturę. Są takie choroby, które atakują limfocyty. Są to często choroby zakaźne – wirusowe. I co ciekawe, lubują się właśnie w interesujących nas limfocytach. Te wirusy należą do lentiwirusów – mniejsza o systematykę ważne, że lubią nasze limfocyty. A gdyby tak rozbroić je, unieszkodliwić i podczepić im właściwy gen? Wtedy to one same znajdą interesujące nas komórki (limfocyty) i dostarczą im zamiast swojego kodu genetycznego, kod który chcemy, żeby się dostał do naszych żołnierzy. Jak wymyślili ci nasi naukowcy, tak zrobili. I… udało się. Limfocyty zobaczyły wroga i zaczęły go niszczyć. Ironią losu jest fakt, że najskuteczniejszymi dostarczycielami (naukowcy mówią na takiego posłańca „wektor”) tego kodu genetycznego, na którym nam zależy, są lentiwirusy, a ich głównym przedstawicielem jest… HIV. Tak to bywa jednak, że natura lubi być czasem trochę przewrotna. I od razu uspokajam – stosowane lentiwirusy w tej procedurze w żadnym wypadku nie wywołują ani AIDS, ani nie są aktywnymi wirusami HIV. Wykorzystuje się tylko ich drobną część, która rozpoznaje limfocyty i dostarcza paczkę odpowiednim genem.

Zdjęcie ilustracyjne / Fot. Shutterstock
Wydawało się, że sukces jest pewny…
Jak to bywa z nauką – rozczarowanie to jej drugie imię. Na początku i owszem limfocyty ochoczo brały się do walki, ale po niedługim czasie stawały się ospałe. Szybko i masowo ginęły w czeluściach guza nowotworowego. A ten spokojnie rozwijał się dalej. Co poszło nie tak?
Nie wystarczy widzieć, trzeba mieć jeszcze tarczę i broń. Bo co z tego, że łobuza widzimy i ruszymy na niego z gołymi pięściami, skoro on ma pistolet? Szanse raczej mamy marne. Zatem co było robić – trzeba oprócz okularów dostarczyć tarczę i karabin maszynowy? Trzeba dodać jeszcze kilka genów, które będą kodować białka walczące z nowotworem. Minęło kilka lat i dopracowaliśmy technologię. Dodaliśmy te geny. I… tym razem udało się! Nowotwór był bez szans. Uzbrojone, dobrze wyszkolone wojska z odpowiednim sprzętem dorwały się do buntowników i tym razem już nie odpuściły.
Historia pisana na naszych oczach
Ta historia to opis naszej walki z nowotworami dosłownie ostatnich lat i miesięcy. Technologia jest nowa i wciąż jeszcze badana. Ogromny sukces terapeutyczny odniesiono na razie tylko w kilku nowotworach – głównie hematologicznych – za to bardzo groźnych, bo np. w ostrej białaczce limfoblastycznej. Historia medycyny pisana jest dosłownie na naszych oczach. Postęp jest bardzo szybki, choć wymaga gigantycznych nakładów czasu, pracy i oczywiście pieniędzy. Ale warto, bo widać wspaniałe efekty.
Technologia rozwija się w zawrotnym tempie, a kolejne generacje komórek układu odpornościowego powstają jak grzyby po deszczu. Wymagają oczywiście bardzo zaawansowanych technologii i niezwykle wyrafinowanych laboratoriów, ogromnego doświadczenia i szeregu badań klinicznych. Prace nad tymi terapiami jednak przyspieszają. Dość powiedzieć, że pierwsza generacja tak zmodyfikowanych limfocytów (mówimy o nich CAR-T) została użyta do terapii w 2012 roku. Zastosowano ją u kilku pacjentów i dotyczyła tylko jednego rodzaju nowotworu. Ściślej rzecz ujmując – jednego tylko antygenu nowotworowego. Dziś mamy już czwartą generację tych komórek, a ilość badanych antygenów przekracza setkę. I nie dotyczą one tylko hematologicznych nowotworów, ale również szeregu innych. Problemem jest fakt, że badania te są niezwykle złożone i wymagają zaangażowania w pracę wielu różnych ośrodków, z których każdy wypełniać musi ściśle określoną funkcję. Nie istnieje ośrodek na świecie, który byłby w stanie całą „produkcję” tych limfocytów przeprowadzić sam. Jeden produkuje zmienione geny, inny posłańców (wektory wirusowe dostarczające zmienione geny pod właściwy adres), jeszcze inny zajmuje się hodowlą zmienionych genetycznie komórek. A do tego muszą istnieć miejsca wyspecjalizowane w podawaniu tych zmodyfikowanych „żołnierzy” chorym, czyli ośrodki badań klinicznych.

Zdjęcie ilustracyjne / Fot. Shutterstock
My też bierzemy w tym udział
Świętokrzyskie Centrum Onkologii w Kielcach też bierze udział w takich badaniach i to w podwójnej roli. Po pierwsze budujemy układ przenośnikowy dla zmodyfikowanych genów (wektor wirusowy), a po drugie jesteśmy ośrodkiem, który będzie prowadził badania kliniczne, czyli będziemy podawać zmodyfikowane limfocyty naszym chorym. Jest to ogromne wyzwanie dla naszego ośrodka, ale też i ogromne wyróżnienie. A przede wszystkim ogromna szansa dla naszych chorych. O komórkach CAR-T napisano dziesiątki tysięcy artykułów i nie sposób w tak krótkim materiale powiedzieć o nich wszystkiego, ale obiecuję, że na bieżąco będę pisał o postępach w badaniach nad nimi w kolejnych felietonach.
Powyższy tekst jest artykułem popularnonaukowym. Zawiera szereg uproszczeń. Proszę zatem wszystkich czytających, aby wzięli to pod uwagę, a jeśli kogoś on zainteresował i wzbudził ochotę do dalszych studiów, to zachęcam do sięgnięcia do literatury fachowej.
Prof. Marcin Pasiarski
Kierownik Kliniki Hematologii, Immunologii i Transplantacji Szpiku Świętokrzyskiego Centrum Onkologii w Kielcach, konsultant wojewódzki w dziedzinie hematologii oraz przewodniczący świętokrzyskiego oddziału Polskiego Towarzystwa Hematologów i Transfuzjologów. W kręgu jego zainteresowań znajdują się techniki związane z tworzeniem nowych rodzajów szczepionek, nowoczesne metody zwalczania chorób nowotworowych oparte o immunoterapię adoptywną oraz leczenie nowotworów z użyciem komórek CAR-T. Wykłada w Collegium Medicum Uniwersytetu Jana Kochanowskiego. Jest fanem Jean’a Michela Jarre’a. Fascynuje się także nowymi technologiami. Uwielbia podróże i jeśli tylko jest okazja bierze plecak i w rusza w drogę.